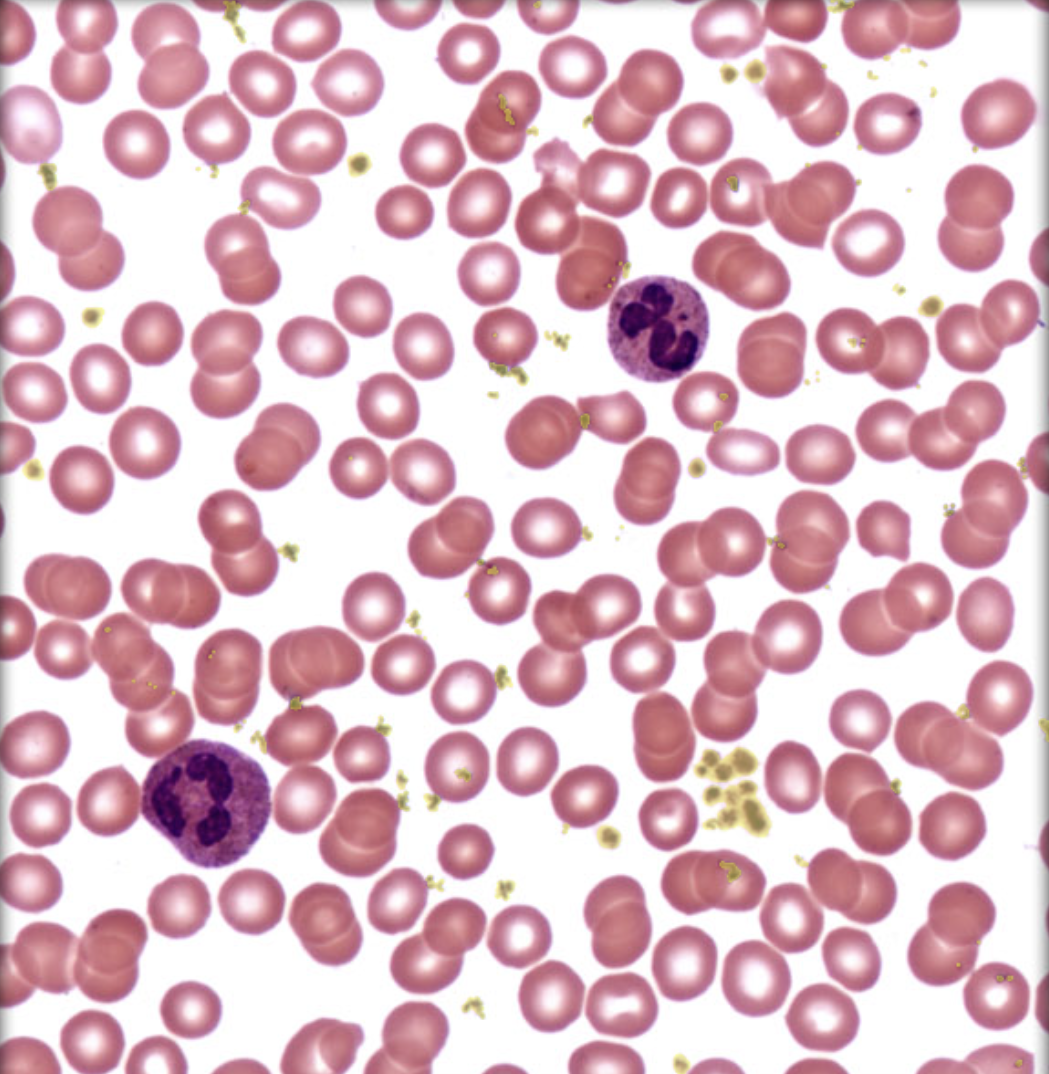

Identify tissue by the image
1/44
There's no tags or description
Looks like no tags are added yet.
Name | Mastery | Learn | Test | Matching | Spaced | Call with Kai |
|---|
No analytics yet
Send a link to your students to track their progress
45 Terms

Identify tissue by the image
Simple Squamous epithelium

Identify tissue by the image
Simple Cuboidal Epithelium

Identify tissue by the image
Ciliated Simple Columnar Epithelium

Identify tissue by the image
Nonciliated simple columnar epithelium

Identify tissue by the image
Keratinized Stratified squamous

Identify tissue by the image
NonKeratinized Stratified Squamous

Identify tissue by the image
Nonciliated pseudostratified columnar epithelium

Identify tissue by the image
Ciliated pseudostratified columnar epithelium

Identify tissue by the image
Transitional Epithelium

Identify tissue by the image
Areolar Connective Tissue

What is the hilighted part?
Areolar Connective Tissue Elastic fiber

What is the hilighted part?
Areolar Connective Tissue Collegen Fiber

Identify tissue by the image
Adipose Connective tissue

What is the hilighted part?
Adipocyte

What is the hilighted part?
Nucleus of Adipocyte

Identify tissue by the image
Reticular connective tissue

What is the hilighted part?
Leukocyte

What is the hilighted part?
Reticular Fiber

What is the hilighted part?
Macrophages

Identify tissue by the image
Dense Regular Connective tissue

What is the hilighted part?
Collegen fiber in dense regular connective tissue

Identify tissue by the image
Dense Irregular connective tissue

What is the hilighted part?
Collegen fiber

What is the hilighted part?
NUcleus of fibropblast

Identify tissue by the image
Elastic connective tissue

What is the hilighted part?
Elastic Lamellae

What is the hilighted part?
Internal Elastic Lamellae

Identify tissue by the image
Hyaline Cartilage

What is the hilighted part?
Extracelluar matrix in hyaline cartilage

What is the hilighted part?
Lacuna (with Chondrocyte) in hyaline cartilage

What is the hilighted part?
Chondrocyte (with lacuna) in hyaline cartilage

Identify tissue by the image
Elastic cartilage

Identify tissue by the image
Fibrocartilage

what is this?
Bone

whats the hilghited part called?
Osteon

What is the highlited part called?
Central canal of osteon

what is the highlited part?
Osteocyte in lacuna

What is this?
Blood
What is this
Platelet

What is this?
Erythrocyte

What is this?
leukocyte

what is this?
Skeletal muscle

what is this?
cardiac muscle

what is this?
cardicac muscle tissue

what is this?
nervous tissue